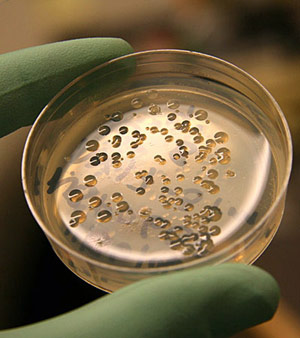
Heterotrophic Plate Count

Alpha Analytical is now supporting drinking
Alpha Analytical is now supporting drinking
water operations with HPC bacteria analyses utilizing a lower
nutrient R2A Agar.
The Heterotrophic Plate Count (SIM Plate
Method) with plate count Agar is the public health
standard for drinking water at the distribution point in a system
(regulatory limit <500count/ml). The Heterotrophic
Plate Count (SM9215) using R2A Agar and a seven day
incubation at room temperature provides a more precise count of water
bacteria that find the relatively lower nutrient count (R2A Agar) to
be inhibitory.